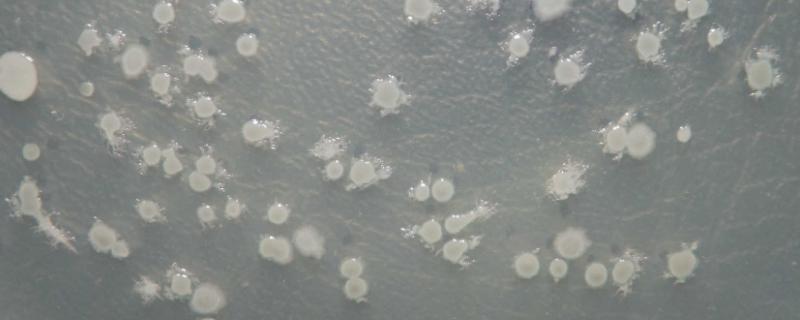
地衣芽孢杆菌对植物，和凝结芽孢杆菌的区别

板栗从哪里来
作者:李宗全
2019-12-16 18:00:25

板栗从板栗树上来。板栗树是高达20米的乔木,外形上和其他果树差别不大,但是果实与很多树不同,其果实有一层厚厚的带刺外壳,壳斗连刺径4.5-6.5厘米,其中包裹的就是日常生活中食用的板栗。
- 问矮化板栗亩产多少斤以早熟、高产的品种为例,其亩产量一般为450公斤左右。板栗是一种属于山毛榉目、壳斗科、栗属、栗种的植物,其品种较多,并且会因为各地的气候、土壤与其它条件的不同而导致树形的高矮、叶背和果壳上的毛被、果实的成熟期、果实的大小和品质都有差异。
- 问板栗快速去皮的方法板栗快速去皮可以洗净之后用开水煮至5分钟左右,取出切开,栗皮会随栗壳一起脱落,还可以将板栗切成两瓣,去壳后放入盆内,加开水浸泡一会儿后,用筷子搅拌,栗皮也会与栗肉脱离。
- 问板栗有几种板栗品种繁多,主要分为北方栗和南方栗。北方栗的主要品种有金丰、海丰、石丰、燕山红栗、红光栗、红栗、早丰、后韩庄20等,南方栗的主要品种有九家种、焦扎、青毛软刺、短扎、处暑红、陈果油栗等。板栗原产我国,是我国食用最早的著名坚果之一,年产量居世界首位。
- 问板栗如何快速去壳可以将板栗放在热水中,然后放入适量的食用盐,盖上锅盖浸泡板栗5分钟左右取出,用剪刀剪开一个口子就可轻松的剥出完整的板栗;用剪刀在板栗外壳上剪上一道口,然后把板栗放入碗中盖上盖子,用微波炉高温加热1分钟后取出,等到板栗稍微冷却一下,用手轻轻一掰,板栗外壳就会被剥出来。
三农问答